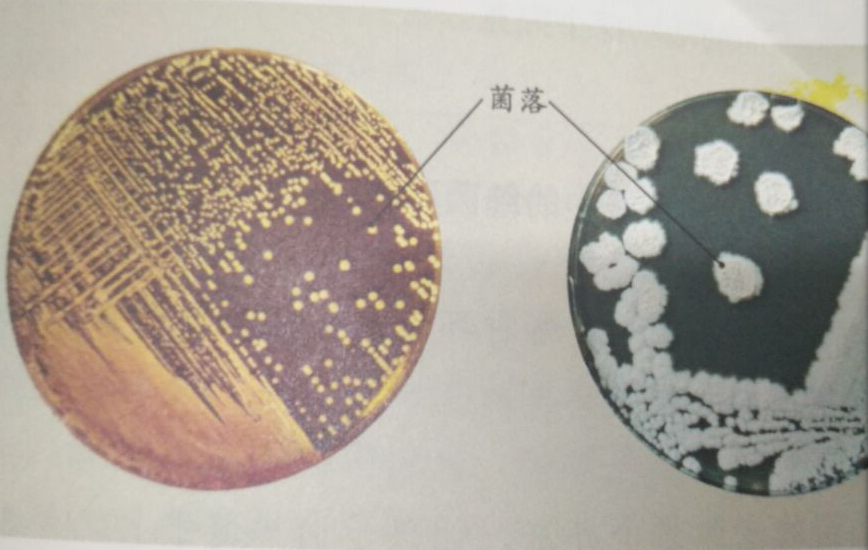

大家好,我是细菌 Hi,你们好吗?我是细菌,接下来我将向你们做自我介绍。 基本信息 我叫细菌,相对于我的大哥"真菌"来说,我的菌落比它的菌落小很多。我的菌落表面光滑湿润或粗糙干燥,用肉眼是看不见我的,必须在显微镜下才能看到我。我的营养方式是异养。因为我不能像植物一样进行光合作用,因此,只能靠吸取外界的营养来生存。

身体结构 我的身体结构也有细胞壁、细胞膜、夹膜、细胞质、DNA。我的身体结构和动物、植物的细胞不同,我没有细胞核,所以是无核生物。我也没有叶绿体,只能利用现成的有机物生活,并把有机物分解为简单的无机物。

作用 我虽体积小,但作用可大着呢! 我作为分解者参与物质循环。例如:当动物和植物死后,我会分解他们的遗体,将他们的遗体分解成水、无机盐和二氧化碳,这样又被植物吸收,植物又被动物也就是消费者吃掉,他们死后又被我分解,他们又利用。这样反反复复,周而复始,就促进了生态系统的物质循环。

形态 我还有很多的形态,例如:球形的叫做球菌,杆形的叫做杆菌,有些弯曲的或呈螺旋状的叫做螺旋菌。每一种不同的形态都有不同的作用哦! 怎么样?听了我的介绍,你们认识我了吗?

大家好,我是细菌 Hi,你们好吗?我是细菌,接下来我将向你们做自我介绍。 基本信息 我叫细菌,相对于我的大哥"真菌"来说,我的菌落比它的菌落小很多。我的菌落表面光滑湿润或粗糙干燥,用肉眼是看不见我的,必须在显微镜下才能看到我。我的营养方式是异养。因为我不能像植物一样进行光合作用,因此,只能靠吸取外界的营养来生存。

身体结构 我的身体结构也有细胞壁、细胞膜、夹膜、细胞质、DNA。我的身体结构和动物、植物的细胞不同,我没有细胞核,所以是无核生物。我也没有叶绿体,只能利用现成的有机物生活,并把有机物分解为简单的无机物。

作用 我虽体积小,但作用可大着呢! 我作为分解者参与物质循环。例如:当动物和植物死后,我会分解他们的遗体,将他们的遗体分解成水、无机盐和二氧化碳,这样又被植物吸收,植物又被动物也就是消费者吃掉,他们死后又被我分解,他们又利用。这样反反复复,周而复始,就促进了生态系统的物质循环。

形态 我还有很多的形态,例如:球形的叫做球菌,杆形的叫做杆菌,有些弯曲的或呈螺旋状的叫做螺旋菌。每一种不同的形态都有不同的作用哦! 怎么样?听了我的介绍,你们认识我了吗?
470 |
0 |
0
总数:0 当前在第1页
